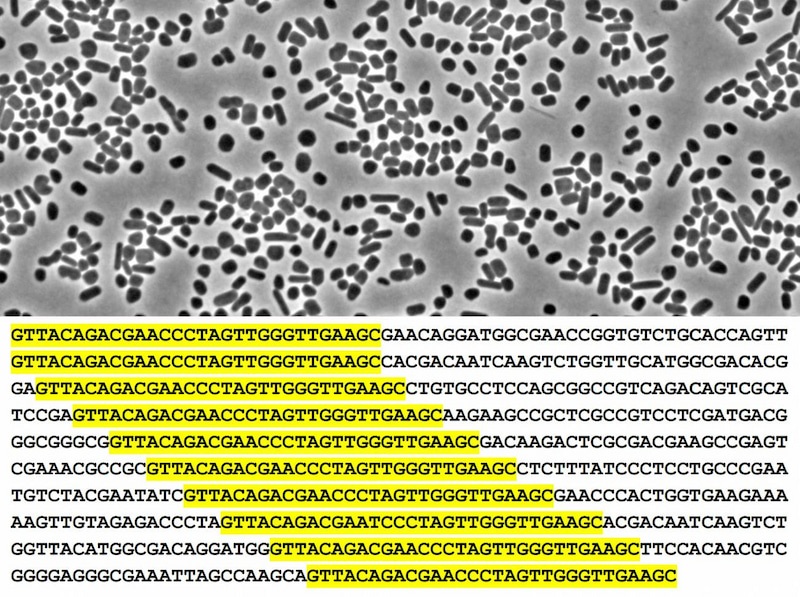
El investigador alicantino dedujo de su hallazgo una idea revolucionaria...

Tribuna de Opinión
Las razones geopolíticas, las del no Nobel para Mojica por su CRISPR y la razón de Biovegen
Gonzaga Ruiz de Gauna Gutiérrez · Director de Biovegen
10/03/2026
De derecha a izquierda, Francisco J. Martínez Mojica -descubridor del CRISPR-, Enmanuelle Charpentier y Jeniffer Doudna -quienes convirtieron su hallazgo en una herramienta clave para la edición genética- posan en la gala poco antes de recibir el Premio 2017 Fundación BBVA Fronteras del Conocimiento en Biomedicina. FOTO CEDIDA POR FUNDACIÓN BBVA.
Hoy es un acrónimo popularizado, usado en miles de artículos científicos y divulgativos, todo un icono de la tecnología más disruptiva. CRISPR engloba las siglas en inglés de Clustered Regularly Interspaced Short Palindromic Repeats, algo así como repeticiones palindrómicas cortas agrupadas y regularmente espaciadas (Sic). Es la nueva técnica de edición genética (NGT, otro acrónimo anglosajón) más prometedora. Piensen en clave de avances médicos, de mejora vegetal o animal, de sostenibilidad ambiental o de reprogramación de microorganismos. Da igual, el CRISPR es la herramienta más precisa, barata, segura, rápida y efectiva para trabajar el genoma de los seres vivos, para editar tanto su ADN (ácido desoxirribonucleico) como en su caso su ARN (ácido ribonucleico). Es, probablemente, el mayor homenaje que la biología se ha dado a sí misma, al menos en lo que llevamos de siglo.
Tan revolucionario que en 2020 mereció el Nobel de Química, que recogieron las dos científicas que han puesto patas arriba a la biología molecular, la estadounidense Jennifer Doudna y la francesa Emmanuelle Charpentier. Pero el manido acrónimo tiene sello español y fue acuñado mucho antes por un investigador alicantino, Francisco Juan Martínez Mojica. Fue en 2002.

El CRISPR-Cas 9 mereció el Nobel de 2020 para las investigadoras Doudna y Charpentier pero el descubrimiento fue muy anterior, de Francis Mojica en 2002
El ecosistema de innovación
Y es aquí, en este ámbito, donde opera Biovegen: trabajamos para que los avances teóricos de la biotecnología agraria se materialicen en patentes, en obtenciones vegetales, en generación de valor y negocio; ayudamos a transformar el conocimiento del científico en soluciones para la empresa, facilitamos -en definitiva- la transferencia tecnológica convirtiendo la investigación básica en investigación aplicada.
Ciertamente, nos hubiera encantado que el descubrimiento de Mojica hubiera concretado en el desarrollo que después fue, que se hubiera dado la colaboración público-privada que tanto intentamos propiciar desde Biovegen y que su hallazgo se hubiera compartido y materializado en mejoras, generando nuevos ingresos para la I+D+i y el agro español.

Porque, justo es decirlo, el catedrático de Microbiología de la Universidad de Alicante descubrió en las rojizas salinas de Santa Pola algo esencial y le puso el nombre que hoy conocemos. Mojica se centró en el estudio de unas arqueas abundantes en ese hábitat, Haloferax mediterranei, y observó en su genoma secuencias repetidas y peculiares. Eran repeticiones cortas, separadas por fragmentos variables, algo que sólo se habían descrito antes en algunas bacterias (Escherichia coli y Mycobacterium sp.). Secuencias que siempre seguían la misma estructura. De ahí realizó dos observaciones revolucionarias: de un lado, planteó que las secuencias que se encuentran entre las repeticiones proceden de elementos genéticos invasores, como virus y plásmidos y del otro, y más determinante que lo anterior, concluyó que dichos espaciadores conferían resistencia a infección por elementos genéticos, conteniendo secuencias que coincidían con las de los propios espaciadores.
Es decir, Mojica planteó que CRISPR es un sistema inmunitario adaptativo de las bacterias, una memoria genética frente a infecciones. Pero fueron Charpentier y Doudna quienes encontraron una aplicación y lo convirtieron en una potente herramienta.
La aportación del alicantino fue teórica y observacional, aunque esencial pero, afortunada o desafortunadamente, el Nobel no parece reconocer los descubrimientos en cadena y según la voluntad original del propio Alfred Nobel, estos premios deben otorgarse a quienes hayan realizado el mayor beneficio para la humanidad.
Proteínas Cas y restricciones

Hoy, décadas después, puedo decir que Biovegen colabora con el propio Mojica en uno de esos proyectos que pudieron haber cuajado entonces pero que aún hoy resultan estratégicos. Nuestra plataforma ha mediado para aunar las capacidades de la Universidad de Alicante -donde ejerce- y de la U. Politécnica de Valencia con la experiencia y know how de la mayor cooperativa hortofrutícola europea, Anecoop así como de la floreciente empresa especializada en CRISPR -sí, ya las hay y es valenciana- Madeinplant.
Hoy, décadas después, Biovegen colabora con el propio Mojica en uno de esos proyectos que pudieron haber cuajado entonces pero que aún hoy resultan estratégicos: nuevas tijeras moleculares alternativas al CRISPR Cas-9 para la mejora de cultivos como el tomate y los cítricos
Porque el lector no versado estará habituado a leer el manido acrónimo -CRISPR- seguido de Cas9. Ese nombre completo (CRISPR-Cas9) es hoy el editor, la tijera molecular más utilizada. Pero, desglosemos. Las siglas Cas significan CRISPR associated, es decir, la proteina asociada. El 9 es el número vinculado a tal enzima (porque cuando se empezaron a caracterizar estos sistemas en bacterias y arqueas, se fueron numerando las proteínas Cas a medida que se descubrían: Cas1, Cas2 Cas9. Y es aquí donde el acceso a la edición genética comienza a restringirse, cuando esa tecnología tan precisa y fiable deja de ser tan barata como venía siéndolo. Es aquí donde se aprecia el coste de oportunidad de que Mojica no se llevara el Nobel: la autoría de las patentes derivadas del CRISPR-Cas9 se reparten entre las dos investigadoras que sí lo obtuvieron -Doudna y Charpentier- y el biólogo molecular chino-estadounidense, Feng Zhang. En la práctica, la disputa -porque ha supuesto un enfrentamiento judicial a gran escala- se da entre los grandes centros a los que se debían estos investigadores: la University of California-Berkeley, la University of Vienna -Austria- y el CNRS -de Francia-, de un lado, y el Broad Institute (MITHarvard), del otro.
Pues bien, la alianza descrita, que cuenta con la financiación del Instituto Valenciano de Calidad e Innovación (IVACE+i) y de la UE pero cuyo investigador de cabecera es el propio Mojica, trabaja en nuevas endonucleasas de ADN tipo Cas (alternativas a la Cas-9) para usarlas en la edición genética de cultivos estratégicos de la Comunidad Valenciana, como variedades de tomate valenciano y, más a largo plazo, cítricos, según reza la descripción del proyecto. Y, según también se asegura, estas nuevas proteínas podrán ser la base para desarrollar herramientas biotecnológicas, no sólo para mejora vegetal, sino también animal y para aplicaciones médicas o de diagnóstico, con gran potencial para tratar enfermedades como ciertos tipos de cáncer, VIH, distrofia muscular o fibrosis quística, y combatir enfermedades infecciosas como la malaria, dengue o la fiebre amarilla.
Los errores de Europa
Insisto, el problema europeo con la biotecnología y las NGTs, no es de falta de inversión o de interés. Ni siquiera se podría decir ahora que hay una falta de conexión entre la investigación básica y la aplicada. Ha sido el desconocimiento primero y la desesperante burocracia comunitaria después, lo que ha dejado en la estacada a nuestra Ciencia.
El pecado original de la UE se remonta a una década antes de que, en 2012, Doudna y Charpentier publicasen el artículo clave que demostraba que CRISPR-Cas9 podía usarse como herramienta programable. Europa comenzó a dar la espalda a la nueva era que se avecinaba a comienzos de este siglo, cuando definió jurídicamente a todo organismo genéticamente modificado (OGM) como aquel cuyo material genético haya sido modificado de una forma que no ocurre naturalmente.
Aquella idea tan alejada de la realidad científica condenó a los transgénicos al ostracismo (sólo en Europa, no así en buena parte del mundo) porque, en la práctica y según se interpretó, sólo importaba cómo se obtiene. Esto es, se castigó al proceso en el laboratorio y no se quiso atender a qué material vegetal se lograba, se puso el foco en regular el procedimiento, la técnica, restringiéndola hasta casi hacerla inviable. La legislación de EEUU, al contrario, atendió al producto editado, la de Argentina se fijó en el rasgo genético concreto logrado, la de Brasil se centró en el resultado y en China, en fin, sus autoridades pronto hicieron de estas investigaciones en todos los campos -también el agrario- una cuestión de Estado con inversiones y medios mastodónticos.
La primera víctima en el viejo continente fueron los transgénicos -que no cuentan en su historial con alerta alimentaria alguna pero sí con una desafortunada denominación y muy mala prensa- pero después las damnificadas fueron las emergentes NGTs, que pasaron a regularse por tan incongruente norma y concepto. Tampoco tenía ni tiene sentido, de otro lado, aplicar las restricciones propias de los transgénicos a los cultivos obtenidos mediante NGTs cuando, en la práctica, es imposible técnicamente diferenciar una variedad editada de otra generada por mutación espontánea, generada por la propia naturaleza, quiere decirse.
Europa se reiteró en aquel error cuando en 2018 el Tribunal de Justicia de la UE dictaminó que un marco legal diseñado en 2001 era aplicable a las técnicas que empezaron embrionariamente a desarrollarse casi una década más tarde. Dos años después de aquel fallo esa misma tecnología mereció, para académicos bastante más versados, el Nobel.

Por eso hoy la mayoría de variedades editadas, los mayores proyectos, inversiones y alianzas empresariales basadas en esta tecnología así como buena parte de las spin off que están floreciendo en torno a ella se producen fuera de la UE. Con honrosas y destacables excepciones, hay que decir. Por eso Europa ha vuelto a tropezar con las NGTs en la misma inconsistencia que ya se dio con los OGMs: que hace inviable su desarrollo científico en la UE mientras comienza a importarse esas mismas variedades, a depender de esas patentes foráneas, que aquí son tan difíciles de impulsar.
Pacto Verde y reorientación

El giro dado sirvió para eliminar cualquier atisbo de duda sobre la conveniencia de dar salida a las NGTs. Los sindicatos agrarios, españoles y europeos, se alinearon a partir de entonces con la comunidad científica para reclamar -clamar, más bien en una sucesión de manifiestos- por una regulación específica para las NGTs. Sólo así el sector primario europeo podría acercarse a cumplir con los objetivos de sostenibilidad del Pacto Verde. Sólo así la agricultura europea podría dar ese salto tecnológico necesario para competir con las importaciones crecientes y más baratas de países terceros. La propia CE encargó un estudio sobre sus posibilidades, recogió información de las consultas con los Estados miembros -entre ellas, la muy favorable al cambio del Ministerio de Agricultura español-, incluyó dictámenes de la European Food Safety Authority (EFSA) y otros organismos que hasta ese momento se habían obviado y concluyó que la legislación actual no está adaptada a los avances científicos y tecnológicos y genera incertidumbre jurídica.

La geopolítica, clave
En ese tiempo de supuesta agilización las circunstancias geopolíticas han vuelto a dar un giro sorprendente. Repasemos. En 2020 la pandemia evidenció la dependencia excesiva de China, la fragilidad logística de un mundo globalizado y la falta de resiliencia industrial europea. En 2022 la invasión de Ucrania por Rusia y la persistencia del conflicto hasta el presente, obligó a Alemania a romper con su proveedor de gas y en la UE se percibió la necesidad de diversificar suministros energéticos, agrícolas y de materias primas.
La llegada de Trump al poder a comienzos de 2025 agravó la incertidumbre generada por la guerra y cuestionó las alianzas militares, la OTAN, el gasto en defensa e incluso las relaciones comerciales transatlánticas. Las sucesivas crisis arancelarias y proteccionistas impulsadas, sus políticas para atraer capitales hacia EEUU y reindustrializar el país, han alimentado la sensación de una Europa aislada, incrementando la necesidad de asegurar mercados de exportación alternativos al norteamericano.
La actitud cautelosamente cercana del régimen chino al del agresor Putin ha obligado a revisar varias veces la condición del gigante asiático, de socio estratégico a competidor y rival sistémico de las democracias occidentales y quizá ahora, otra vez, a inevitable compañía para ganar autonomía frente al capricho de Trump. Las tensiones con Rusia y el cambio en las relaciones con China, por otra parte, han servido para hacer más palmaria la dependencia europea en tierras raras, baterías de litio, componentes industriales y chips-imprescindibles para el cambio verde deseado y para la era digital-, fertilizantes -para el agro- o principios activos farmacéuticos -para esta potente industria europea-.
Las NGTs son un arma
¿Y qué tiene que ver tal macroanális con las NGTs? Todo. Tanto es así que los objetivos del plan de la Granja a la Mesa han sido cuestionados y nadie hoy augura que se cumplirán en 2030.
¿Implica tal cosa que es menos imperativo lograr variedades y mejoras biotecnológicas más adaptadas al cambio climático, resistentes a plagas y enfermedades, que requieran de menos plaguicidas o que sean más productivas sin necesidad de tantos fertilizantes? Es obvio que no, que para competir en nuestro propio mercado con los cereales, frutas y hortalizas de países que ya tenían facilidad de acceso a la UE -como Ucrania, Egipto, Marruecos, Sudáfrica, Turquía - más los que ahora pasarán a tenerlo -como Brasil, Argentina, Australia o en el futuro, la India (cuando modernice su sector primario)- es más necesario que nunca el salto de competitividad que pueden dar al agricultor.

Calendario
Queda mucha letra pequeña que dilucidar, por eso el derecho se ha situado ahora en primer plano. El tránsito entre la consideración de NGT-1 (que se verán favorecidos por la nueva normativa más flexible) y NGT-2 (que sufrirán restricciones casi al mismo nivel que los OGMs) está por concretarse, la convivencia entre el modelo de patentes industriales y el derecho de obtención para las nuevas variedades y mejoras debe aclararse
Biotecnología-derecho-geolopolitica

Biovegen va a llevar estos debates y poner luz sobre esta compleja regulación a los agricultores, los investigadores y empresarios concernidos. El día 3 participé en eI I Congreso de Biotecnologia y Derecho para, de la mano de Lluis Montoliu, biólogo, brillante investigador del CSIC en el Centro Nacional de Biotecnología y gran divulgador y de Ana Judith Martín, coordinadora de Área y Secretaria del Consejo Interministerial de OMG pero, sobre todo, la gran protagonista ejecutora de la política española en favor de las NGTs. Compartiremos reflexiones sobre el verdadero alcance de esta legislación. Se hablará de biotecnología y de cómo en su desarrollo está incidiendo la geopolítica. En ese contexto se entiende, por ejemplo, la presencia en estas jornadas de Juan A. Moliner González, general de división retirado del Ejército del Aire y del Espacio.
De ser, en la práctica, boicoteada por su regulación, la biotecnología europea ha pasado a ser considerada una prioridad en materia de seguridad internacional, incorporada a instancias de la propia OTAN por la UE como tecnología crítica para mantener la ventaja militar y dotada con un programa específico llamado DIANA (Defense Innovation Accelerator for the Nort Atlantic).
Es más, la UE -de manera paralela al desarrollo de la nueva regulación de NGTs para cultivos pero también en cuanto a microorganismos editados (MMGs) y para la medicina humana- acaba de lanzar otra nueva macroiniciativa para impulsar la soberanía tecnológica y reducir dependencias externas (STEP, Strategic Technologies for Europe Platform). Una plataforma que se basa en tres pilares tecnológicos que se retroalimentan: la Inteligencia Artificial, computación cuántica, microelectrónica y robótica; las Clean tech (energías renovables, captura de carbono, baterías ) y claro, la biotecnología aplicada a la salud humana y a la agricultura.
Dos días después de debatir todo ello -el 5 de marzo- el Centro de Biotecnología y Genómica de Plantas (UPM-INIA/CSIC, en Madrid), referente en colaboración ciencia-empresa y socio activo de Biovegen, acogió la Jornada CBGP-EMPRESA: Ciencia e Innovación de vanguardia para una agricultura sostenible. Y el 28 de mayo, en Valencia, será el turno para otro de los grandes de la investigación en NGTs de nuestro país, el Instituto de Biología Celular y Molecular de Plantas (IBMCP) con el que co-organizamos la III Jornada IBMCP-EMPRESAS Innovando el futuro de la biotecnología vegetal. La agenda de este año de Biovegen, el trabajo sobre el terreno en favor de la transferencia de tecnología de las NGTs, será intensa.























